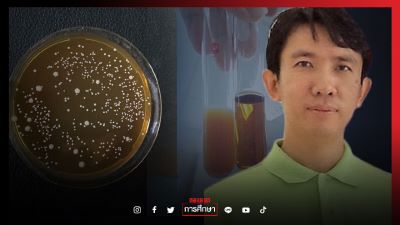
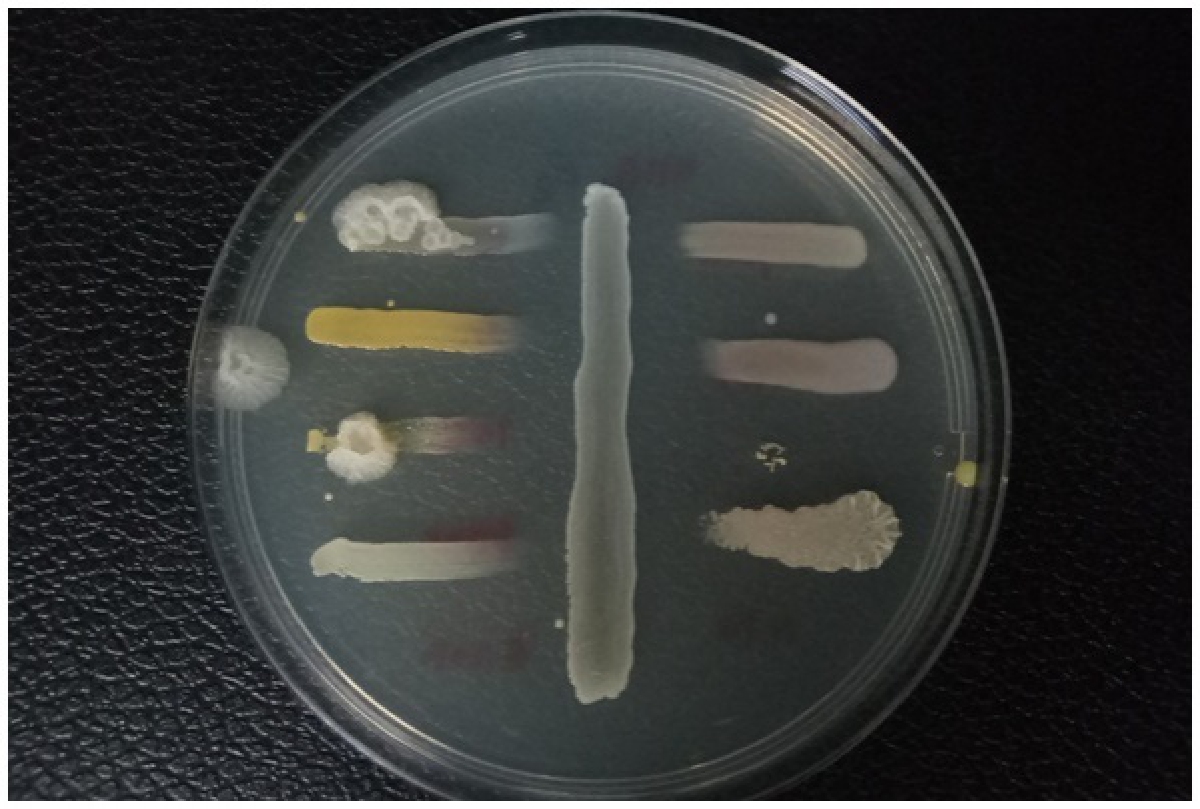
นักวิจัย มวล.พัฒนา "กล้าเชื้อผงปลาส้ม" ทำให้ผลิตปลาส้มได้ทุกฤดูกาล
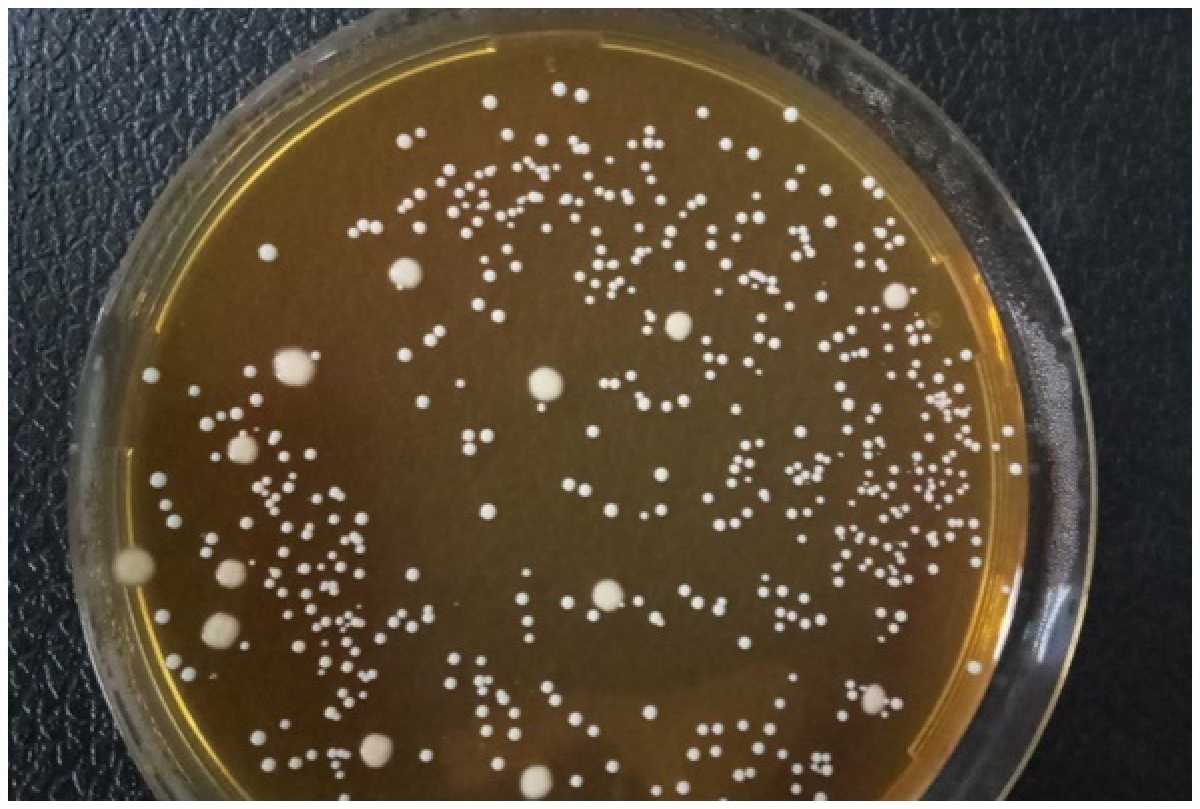
นักวิจัย มวล.พัฒนา "กล้าเชื้อผงปลาส้ม" ทำให้ผลิตปลาส้มได้ทุกฤดูกาล

#SootinClaimon.Com : ขอบคุณแหล่งข้อมูล : หนังสือพิมพ์คมชัดลึก
https://www.komchadluek.net/news/edu-health/478359
“เรียนออนไลน์” แพะรับบาปวงการศึกษาไทย ยุคโควิด-19
11 สิงหาคม 2564 – 17:25 น.
“เดี๋ยวมันก็ผ่านไป” เพราะประโยคนี้ หรือไม่ ทำให้ “การเรียนออนไลน์” ไม่ประสบความสำเร็จ บทวิเคราะห์ โดยชัยวัฒน์ ปานนิล
การเรียนการสอนรูปแบบออนไลน์ กำลังเป็นแพะวงการศึกษาไทย ในสถานการณ์การระบาดของเชื้อไวรัสโคโรนา 2019 (COVID-19)โควิด-19 เพราะตลอดระยะเวลา ที่มีการระบาดของ โควิด-19 ไม่ว่าจะเป็นช่วงเวลาไหน
อ่านข่าวที่เกี่ยวข้อง :
“เรียนออนไลน์”พบทั้งครูและนักเรียนร้อยละ 50 ไม่พร้อม
สิ่งที่ต้องมาก่อนเสมอ คือ การปิดสถานศึกษา แม้ว่าจะได้รับผลกระทบหรือไม่ก็ตาม จนกระทั่งในการระบาดระลอกที่ 3 มีความชัดเจนว่า ส่งผลต่อการจัดการเรียนการสอนอย่างชัดเจน มีการปิดสถานศึกษาเป็นวงกว้าง และยาวนาน
มีบุคคลสำคัญของวงการศึกษา รวมทั้งผู้บริหารระสูงของกระทรวงศึกษาธิการ มากล่าวต่อสาธารณะว่า อาจจะมีการหยุดเรียนยาวทั้งปี หรือปีนี้อาจจะไม่ได้มาโรงเรียนเลย จนกระทั่งมีนักวิชาการการศึกษา เสนอ ยาแรง ถึงขั้น หยุดเรียนเป็นเวลา 1 ปี
เมื่อวันที่ 8 สิงหาคม ศ.ดร.สมพงษ์ จิตระดับ นักวิชาการด้านการศึกษา เปิดเผยว่า จากที่หลายฝ่ายคาดการณ์ว่าจากการแพร่ระบาดของโรคติดเชื้อไวรัสโคโรนาสายพันธุ์ใหม่ 2019 หรือโควิด-19 อาจจะส่งผลกระทบให้นักเรียนอาจต้อง “เรียนออนไลน์” อย่างน้อย 1-2 ปีนั้น มองว่าอาจเกิดขึ้นได้จริง
แต่ขณะนี้ปัญหาใหญ่ของการ“เรียนออนไลน์” คือ เด็กทั่วประเทศโดด“เรียนออนไลน์” กว่า 20% ทำให้เห็นว่าการ”เรียนออนไลน์” ทำให้เด็กเครียดจนต้องโดดเรียน ดังนั้น ถ้ายังจะต้อง“เรียนออนไลน์” ต่ออีก 1 ปี คิดว่าการศึกษาไทยน่าเป็นห่วงอย่างมาก ทั้งในเชิงคุณภาพ ความถดถอยทางการศึกษา และสุขภาพจิตของเด็กที่เป็นผู้เรียน
ศ.ดร.สมพงษ์ ระบุว่า ระบบการศึกษาไทยเป็นระบบอนุรักษ์นิยม ที่ติดกรอบ ติดระเบียบไปหมด บวกกับความกลัวการแพร่ระบาดขอเชื้อโควิด-19 ทำให้ระบบการศึกษาหดตัว ถดถอย จึงกลายเป็นความกลัวเกินเหตุ ทำให้การจัดการศึกษาไม่ตอบสนองกับปัญหาที่เกิดขึ้นจริง สถานศึกษาต้องปรับการเรียนการสอนตาม 5 รูปแบบที่ ศธ.กำหนด คือ On-site, On-air, On-demand, On-line และ On-hand แทนการสอบปกติแทบทั้งหมด
(อ้างอิง จาก https://www.matichon.co.th/education/news_2873877 )
การเรียนการสอนในรูปแบบออนไลน์ หรือ“เรียนออนไลน์” ไม่ได้ล้มเหลวอย่างสิ้นเชิง เพียงแต่ไม่ประสบความสำเร็จตามที่สังคมคาดหวัง เมื่อเรามองไปที่โรงเรียน ซึ่งเป็นหน่วยจัดการเรียนการสอนในรูปแบบออนไลน์ จริงๆ จะสามารถวิเคราะห์ ได้ว่า การที่การเรียนการสอนในรูปแบบออนไลน์ ไม่เป็นไปตามที่สังคมคาดหวัง เพราะอะไร
อาจเป็นเพราะวิสัยทัศน์ ของผู้บริหารที่มองว่า โควิด-19 “เดี๋ยวมันก็ผ่านไป” ทำให้ขาดการวางแผนในระยะยาวที่เป็นระบบ แถมยังยึดติดในระเบียบเดิมๆ ไม่มีการปรับเปลี่ยน ไม่มีการเปลี่ยนแปลง มองว่า การระบาดของเชื้อไวรัสโควิด-19 เป็นเพียงสถานการณ์ระยะสั้น “ เดี๋ยวมันก็ผ่านไป” เราต้องอดทน ผ่านมันไปด้วยกัน
เมื่อเป็นเช่นนั้น ในระดับปฏิบัติมีหลายแห่งที่เกียร์ว่าง รอโรงเรียนเปิดเรียนแล้วสอนในชั้นเรียนเป็นการชดเชยให้กับเด็ก อย่างที่เคยทำในการระบาดระลอกแรก จะเห็นได้จากการที่ สำนักงานคณะกรรมการการศึกษาขั้นพื้นฐาน(สพฐ.) ไม่ยอมปรับเปลี่ยนแม้กระทั่ง วันปิด-เปิด ของแต่ละภาคเรียน ในปีการศึกษา 2564
ความไม่ชัดเจนในการสั่งการและวิธีปฏิบัติ เป็นอีกหนึ่งปัญหา ที่ทำให้การจัดการเรียนการสอน ของสถานศึกษาในสถานการณ์การระบาดของเชื้อไวรัสโควิด-19 ล้มเหลว การที่กระทรวงศึกษาธิการมองว่า ปัญหาโควิด-19 เป็นปัญหาระดับพื้นที่ ที่มีความแตกต่างกัน มีบริบทที่ไม่เหมือนกัน
จึงมอบอำนาจการตัดสินใจในการวางแผนดำเนินการและแก้ปัญหา ไว้กับผู้อำนวยโรงเรียน ภายใต้การอนุมัติของ ศูนย์บริหารสถานการณ์แพร่ระบาดของโรคติดเชื้อไวรัสโคโรนา 2019 ระดับจังหวัด (ศบค.จังหวัด)
และการกำกับติดตามของสำนักงานเขตพื้นที่การศึกษา(สพท.) ส่งผลให้การดำเนินการแต่ละพื้นที่แตกต่างกัน บางที่ปิดเรียนยาว บางพื้นที่ก็ยังเปิดเรียนตามปกติ จึงจะส่งผลต่อนักเรียนที่ต้องศึกษาต่อในระดับสูงขึ้นไป อาจจะจบเรียนไม่พร้อมกัน ทำให้เกิดความเหลื่อมล้ำทางการศึกษาที่หลายคนชอบพูดถึงกัน
ความไม่พร้อมของครูผู้สอนและนักเรียนในหลายๆ ด้าน จำแนกจาก ระดับชั้นในการจัดการเรียนการสอน ระดับปฐมวัย(อนุบาล1-อนุบาล 3) และระดับชั้นประถมศึกษา ป. 1 – ป. 3 ไม่พร้อมอย่างยิ่งสำหรับการเรียนการสอนในรูปแบบออนไลน์ หากเรียนได้จำเป็นต้องมีผู้ปกครองช่วยเหลือดูแลเป็นพิเศษ ก็จะเป็นปัญหาต่อเนื่องไปอีก
ระดับประถมศึกษาตอนปลาย ถึงมัธยมศึกษาตอนต้น พอเรียนได้ แต่ก็จะมีปัญหาในเรื่องของ อุปกรณ์การเรียน อยากบอกให้ทราบว่า ในปีการศึกษานี้ โรงเรียนยังแจกสมุด ดินสอ ให้กับนักเรียนอยู่สำหรับงบสื่อการเรียนการสอน ซึ่งน่าจะปรับเปลี่ยนตามสถานการณ์ได้แล้ว
นอกจากปัญหาด้านอุปกรณ์แล้ว ยังมีปัญหา เรื่อง อินเตอร์เน็ต ค่าใช้จ่ายต่างๆ ที่เพิ่มมา และด้วยวัยของเด็ก ทำให้มีความยากที่จะตั้งใจเรียน เหมือนกับการเรียนในชั้นเรียน
ความไม่พร้อมของผู้ปกครอง ครอบครัวไทย สมัยใหม่ เป็นครอบครัวเดียว อยู่กัน 2-5 คน พ่อ แม่ ลูก ในเมื่อพ่อ แม่ ต้องทำงานหาเลี้ยงครอบครัว ก็ไม่สามารถที่จะดูแลลูกๆ ให้เข้า”เรียนออนไลน์” ได้ทุกชั่วโมง ทำให้เกิดปัญหา นักเรียนไม่เข้าเรียนออนไลน์
สุดท้าย คือ ความไม่พร้อมของรูปแบบการเรียนการสอนออนไลน์ ด้วยความคิดที่ว่า “เดี๋ยวมันก็ผ่านไป” ทำให้ครูนำรูปแบบการเรียนการสอนในชั้นเรียนตามปกติมาใช้กับการเรียนการสอนแบบออนไลน์
ครูอยู่หน้าจอคอมพิวเตอร์ แล้วสอนนักเรียนเหมือนอยู่หน้ากระดานดำ นักเรียนเรียนที่บ้านแล้วคิดว่าอยู่ในห้องเรียน ไม่เหมือนก็แค่ไม่ได้ใส่ชุดนักเรียน ซึ่งก็มีในเห็นมาแล้วในช่วงแรกๆ ที่ให้นักเรียนใส่ชุดนักเรียน นั่งเรียนออนไลน์ เมื่อแนวคิดไม่เปลี่ยน วิธีการไม่เปลี่ยน ผลลัพธ์ที่ได้ก็คงไม่เปลี่ยน
“ถ้าระเบียบ ทำให้ประชาชนต้องตาย เพราะไม่มีที่กักตัว โปรดจงก้าวข้ามระเบียบนั้น แล้วบอกว่า ต้องทำ เพราะผมเป็นคนสั่งเอง ให้มันรู้ไปว่าระเบียบ กับ ความตายอะไรสำคัญกว่า” นายวีระศักดิ์ วิจิตร์แสงศรี ผู้ว่าราชการจังหวัดสมุทรสาคร เคยกล่าวไว้ กระทรวงศึกษาธิการก็อยากได้คนกล่าวเช่นนี้เหมือนกัน
ก้าวข้ามกฎระเบียบ สร้างความเปลี่ยนแปลง เพื่ออนาคตของเด็กไทย ยังไม่สายที่จะลงมือทำดีกว่าบอกแค่ว่า “เดี๋ยวมันก็ผ่านไป”